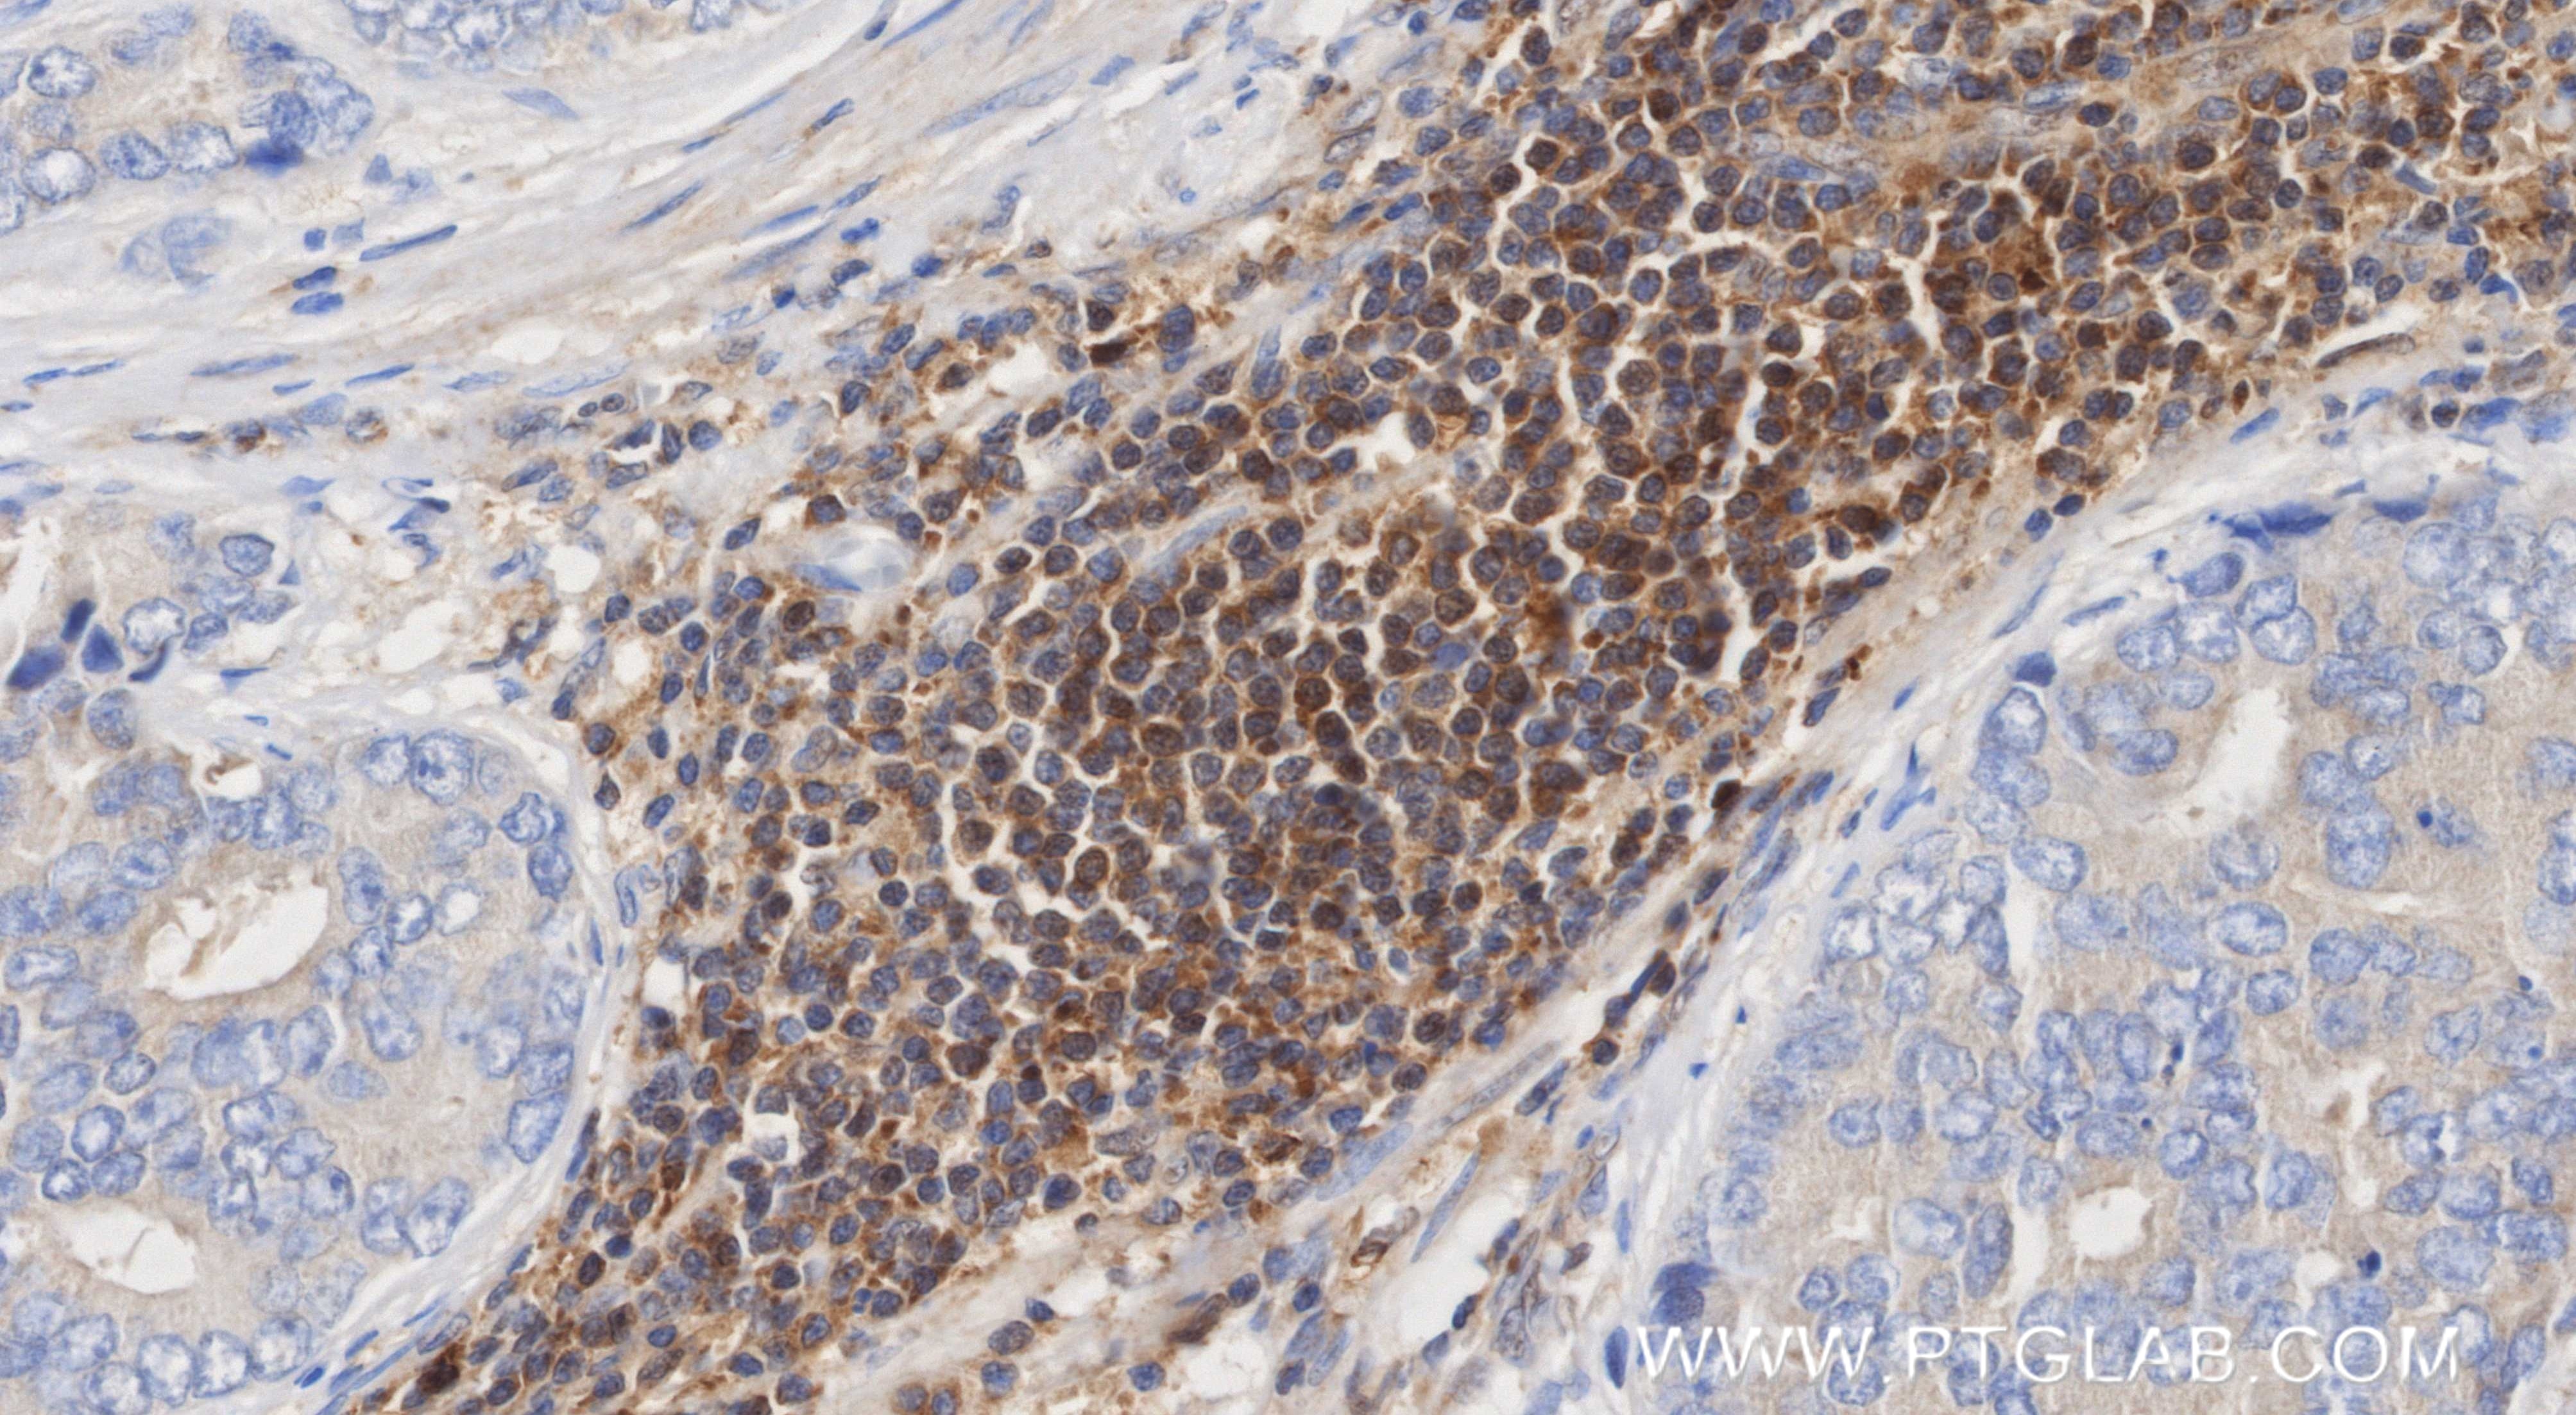
Immunohistochemistry (IHC) staining of human prostate cancer tissue using NFKB1 p105/p50-Specific Recombinant monoclonal ant (81261-2-RR)

Validation Data Gallery
Tested Applications
Recommended dilution
| Application | Dilution |
|---|---|
| It is recommended that this reagent should be titrated in each testing system to obtain optimal results. | |
Product Information
81261-2-PBS targets NFKB1 p105/p50-Specific as part of a matched antibody pair:
MP03001-1: 81261-2-PBS capture and 81261-3-PBS detection (validated in Sandwich ELISA)
Unconjugated rabbit recombinant monoclonal antibody in PBS only (BSA and azide free) storage buffer at a concentration of 1 mg/mL, ready for conjugation. Created using Proteintech’s proprietary in-house recombinant technology. Recombinant production enables unrivalled batch-to-batch consistency, easy scale-up, and future security of supply.
This conjugation ready format makes antibodies ideal for use in many applications including: ELISAs, multiplex assays requiring matched pairs, mass cytometry, and multiplex imaging applications.Antibody use should be optimized by the end user for each application and assay.
| Tested Reactivity | human |
| Host / Isotype | Rabbit / IgG |
| Class | Recombinant |
| Type | Antibody |
| Immunogen |
Peptide 相同性解析による交差性が予測される生物種 |
| Full Name | nuclear factor of kappa light polypeptide gene enhancer in B-cells 1 |
| Calculated molecular weight | 105 kDa |
| Observed molecular weight | 50 kDa, 105 kDa |
| GenBank accession number | NM_003998 |
| Gene Symbol | NFKB1 |
| Gene ID (NCBI) | 4790 |
| Conjugate | Unconjugated |
| Form | |
| Form | Liquid |
| Purification Method | Protein A purification |
| UNIPROT ID | P19838 |
| Storage Buffer | PBS only{{ptg:BufferTemp}}7.3 |
| Storage Conditions | Store at -80°C. |
Background Information
NFkB is a pleiotropic transcription factor which is present in almost all cell types and is involved in many biological processed such as inflammation, immunity, differentiation, cell growth, tumorigenesis and apoptosis. NFkB is is activated by various intra and extra cellular stimuli such as cytokines, oxidant free radicals, ultraviolet irradiation, and bacterial or viral products. NFkB is a family of transcription factors that consists of homo and heterodimers of NFkB1/p50 and RelA/p65 subunits, and controls a variety of cellular events including development and immune responses. All members share a conserved amino terminus domain that includes dimerization, nuclear localization, and DNA binding regions, and a carboxy terminal transactivation domain. Serines 529 and 536 in the transactivation domain of RelA/p65 are phosphorylated in response to several stimuli including phorbol ester, IL1 alpha and TNF alpha as mediated by IkB kinase and p38 MAPK. Phosphorylation of serines 529 and 536 is critical for RelA/p65 transcriptional activity. Activated NFkB translocates into the nucleus and stimulates the expression of genes involved in a wide variety of biological functions. Inappropriate activation of NFkB has been associated with a number of inflammatory diseases while persistent inhibition of NFkB leads to inappropriate immune cell development or delayed cell growth. NFKB1 appears to have dual functions such as cytoplasmic retention of attached NF-kappa-B proteins by p105 and generation of p50 by a cotranslational processing. This antibody can bind both p105 and p50 isoforms of NFKB1.